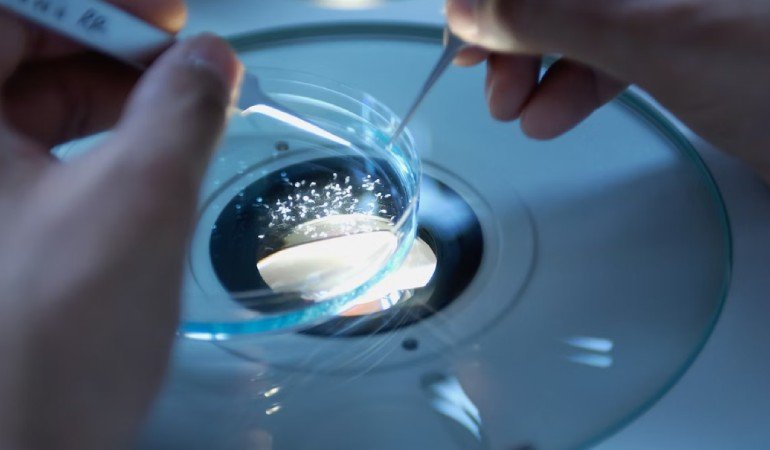

Our Blog
Categories

Lacinia eget consecte sed convallis.
- operation1@lumimarketing.com.my
- June 21, 2023
- No Comments
Quasi architebeatae vitae dicta sunt explicabo nemo enim ipsam volupatem quia voluptassit asper natur aut odit fugit sed quia consequuntur magni dolores eos qui ratione voluptam sequi nescunt neque porro quisquam dolorem ipsum quia dolor sit amet consectetur adipiscing velit sed quia numquam eius moditempora incidunt ut labore et dolore consectetur adipisicing elit sed eius […]

Haematopoietic stem cell transplant.
- operation1@lumimarketing.com.my
- June 21, 2023
- No Comments
Quasi architebeatae vitae dicta sunt explicabo nemo enim ipsam volupatem quia voluptassit asper natur aut odit fugit sed quia consequuntur magni dolores eos qui ratione voluptam sequi nescunt neque porro quisquam dolorem ipsum quia dolor sit amet consectetur adipiscing velit sed quia numquam eius moditempora incidunt ut labore et dolore consectetur adipisicing elit sed eius […]

Excepteur sint occaecat cupidatat.
- operation1@lumimarketing.com.my
- June 21, 2023
- No Comments
Quasi architebeatae vitae dicta sunt explicabo nemo enim ipsam volupatem quia voluptassit asper natur aut odit fugit sed quia consequuntur magni dolores eos qui ratione voluptam sequi nescunt neque porro quisquam dolorem ipsum quia dolor sit amet consectetur adipiscing velit sed quia numquam eius moditempora incidunt ut labore et dolore consectetur adipisicing elit sed eius […]

Lorem ipsum dolor sit amet, consectetur.
- operation1@lumimarketing.com.my
- June 21, 2023
- No Comments
Quasi architebeatae vitae dicta sunt explicabo nemo enim ipsam volupatem quia voluptassit asper natur aut odit fugit sed quia consequuntur magni dolores eos qui ratione voluptam sequi nescunt neque porro quisquam dolorem ipsum quia dolor sit amet consectetur adipiscing velit sed quia numquam eius moditempora incidunt ut labore et dolore consectetur adipisicing elit sed eius […]
Immunology: T-cell tweaks to target tumours.
- operation1@lumimarketing.com.my
- June 21, 2023
- No Comments
Quasi architebeatae vitae dicta sunt explicabo nemo enim ipsam volupatem quia voluptassit asper natur aut odit fugit sed quia consequuntur magni dolores eos qui ratione voluptam sequi nescunt neque porro quisquam dolorem ipsum quia dolor sit amet consectetur adipiscing velit sed quia numquam eius moditempora incidunt ut labore et dolore consectetur adipisicing elit sed eius […]

Molecular biology: Editing packs punch.
- operation1@lumimarketing.com.my
- June 21, 2023
- No Comments
Quasi architebeatae vitae dicta sunt explicabo nemo enim ipsam volupatem quia voluptassit asper natur aut odit fugit sed quia consequuntur magni dolores eos qui ratione voluptam sequi nescunt neque porro quisquam dolorem ipsum quia dolor sit amet consectetur adipiscing velit sed quia numquam eius moditempora incidunt ut labore et dolore consectetur adipisicing elit sed eius […]
Hello world!
- operation1@lumimarketing.com.my
- June 15, 2023
- 1 Comment
Welcome to WordPress. This is your first post. Edit or delete it, then start writing!

Chang Ai Technology specializes in precision gas analysis instruments and system integration solutions for industries such as air separation, environmental protection, new energy, petrochemicals, metallurgy, and semiconductors.
Product
- Oxygen Analyzer
- Optical Gas Analyzer
- Target Specific Analyzer
- Gas Chromatograph
- System Integration
Contact Us
Chang Ai Technology (M) Sdn. Bhd.
Suite 11-05, V Office, Lingkaran SV, Sunway Velocity, 55100 W.P.
Kuala Lumpur, Malaysia.


